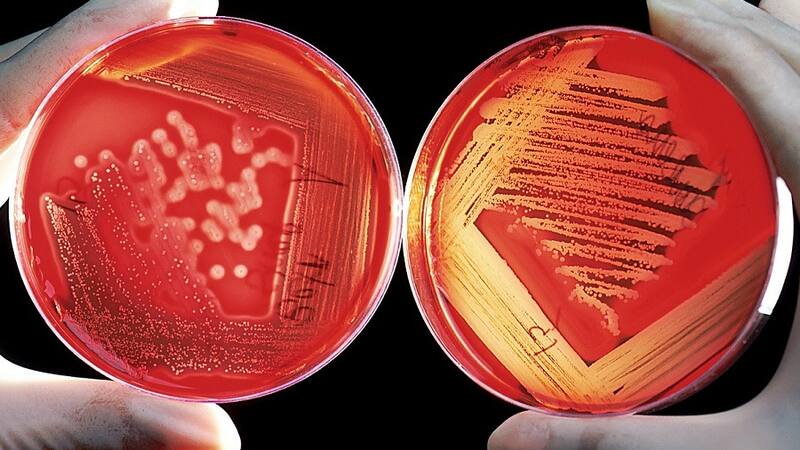

Por Qué Pasa de La Tercera¿Cómo cambian de forma las células y los tejidos? Científicos chilenos crean un fascinante modelo que predice esta transformación
Investigación multidisciplinaria, liderada por Fernanda Pérez, doctora en Física del del Núcleo Milenio Física de la Materia Activa y del DFI-FCFM-UChile, podría impactar en los procesos que originan órganos defectuosos o generar terapias no invasivas para el cáncer.
En biología, la morfogénesis es el área que estudia el origen de la forma de los distintos órganos del cuerpo. Su investigación es muy importante, porque permite a los científicos entender la formación de estructuras y órganos: datos clave para conocer más sobre el desarrollo embrionario, la formación de órganos defectuosos, etc. Fernanda Pérez, física de la Universidad de Chile y doctorada a principios de año en el Núcleo Milenio Física de la Materia Activa y Departamento de Física de la FCFM-UChile, lidera una investigación multidisciplinaria en la que analizando el desarrollo embrionario de peces anuales ha logrado crear un modelo matemático que permite aplicar conceptos físicos a esta área de la biología, que podrían impactar -a largo plazo- en áreas tan importantes como las terapias contra el cáncer.
La investigación está disponible en esta cápsula animada, que te la explica en menos de 2 minutos.
Drásticos cambios
En su primera investigación, en 2019, Fernanda Pérez, junto al investigador francés Jean-Francois Joanny y su director de tesis, doctor Rodrigo Soto, estudió el tejido exterior del pez anual. Hasta entonces, los experimentos revelaban que en el desarrollo embrionario de este pez -50 horas después de la fertilización- sus células sufrían contracciones. El objetivo era ver si se podían describir las fuerzas físicas que allí actuaban.
Para eso, se usó el modelo de vértices, ya conocido, que describe los tejidos como un embaldosado de polígonos, donde cada polígono es una célula. La idea era recrear estas contracciones de las células en una simulación computacional para tratar de entender qué pasaba en las células para que esta actividad ocurriera. Para eso, Pérez y su equipo, agregaron algo nuevo al modelo: aplicaron actividad en las células, dado que en la vida real estas se contraen y expanden.
Lo que descubrieron es que cuando se incluye esta actividad, el tejido puede volverse inestable y que esa inestabilidad transforma los tejidos y hace que las células cambien drásticamente de forma, efecto que pudieron calcular con precisión. Lo mismo ocurría cuando el tejido era estirado o comprimido externamente. Estos resultados fueron publicados en el año 2020 en la revista Physical Review E.
Geometría celular
En una segunda investigación, en 2021, Pérez junto a los investigadores del Núcleo Milenio Física de la Materia Activa, Rodrigo Soto (físico) y Miguel Concha (biólogo), además de German Reig (biólogo) y Mauricio Cerda (ingeniero en computación), descubrió que las células cambiaban su geometría dependiendo del lugar donde se ejercía la fuerza mecánica sobre ellas: cuando la fuerza o actividad se ejercía en el centro de la célula, estas se volvían alargadas y cuando se ejercía en su perímetro, se volvían circulares.
Esto le permitió los científicos, solo mirando la forma o geometría de la célula, indicar cuál era el tipo de actividad celular a la que estaban siendo sometidas. Estos resultados fueron publicados en el año 2022 en la revista Interface de la Royal Society.
A través de simulaciones numéricas, encontraron también, que las fluctuaciones en la red de proteínas a nivel celular generan movimientos colectivos en el tejido, en forma de compresiones en distancias más grandes, lo que podría dar lugar a las deformaciones que se generan en órganos nuevos.
“Si estas inestabilidades y transformaciones geométricas que descubrimos ocurren en la naturaleza, como dice nuestro modelo, podría permitirnos saber qué propiedades del sistema debemos modificar para anular estos procesos, si se quiere evitar esa deformación, por ejemplo, en el caso de un órgano que se está formando erróneamente”, dijo la doctora Fernanda Pérez.
Y agregó que los resultados de la investigación también podrían impactar, a largo plazo, en terapias contra el cáncer. “Cuando un tejido se vuelve inestable busca reaccionar, produce divisiones o muerte celular. En el cáncer las células están vueltas locas, porque hay una inestabilidad y las células generalmente no hacen eso. Si podemos manejar esa inestabilidad utilizando estímulos mecánicos como elongar o expandir un poco los tejidos o someterlos a presión, podríamos tener a futuro nuevos tipos de terapia no invasivas contra el cáncer”, asegura.
Por eso, el objetivo final de este trabajo de investigación es lograr establecer una teoría de tejidos que permita hacer predicciones cuantitativas sobre estos fenómenos, dice Pérez.
COMENTARIOS
Para comentar este artículo debes ser suscriptor.
Lo Último
Lo más leído
Plan digital + LT Beneficios por 3 meses
Comienza el año bien informado y con beneficios para ti ⭐️$3.990/mes SUSCRÍBETE













